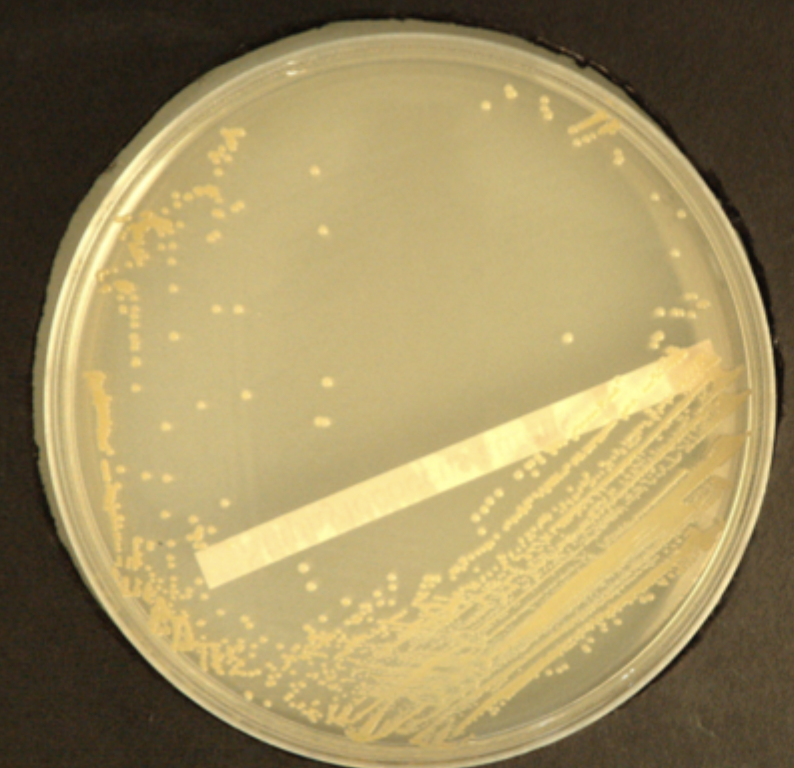
<p>Golden yellow</p><p>Opaque</p><p>Convex</p><p>Round colonies with sharp,clear edges</p><p>Coagulase positive</p><p>Catalase positive</p><p>Gram +</p>
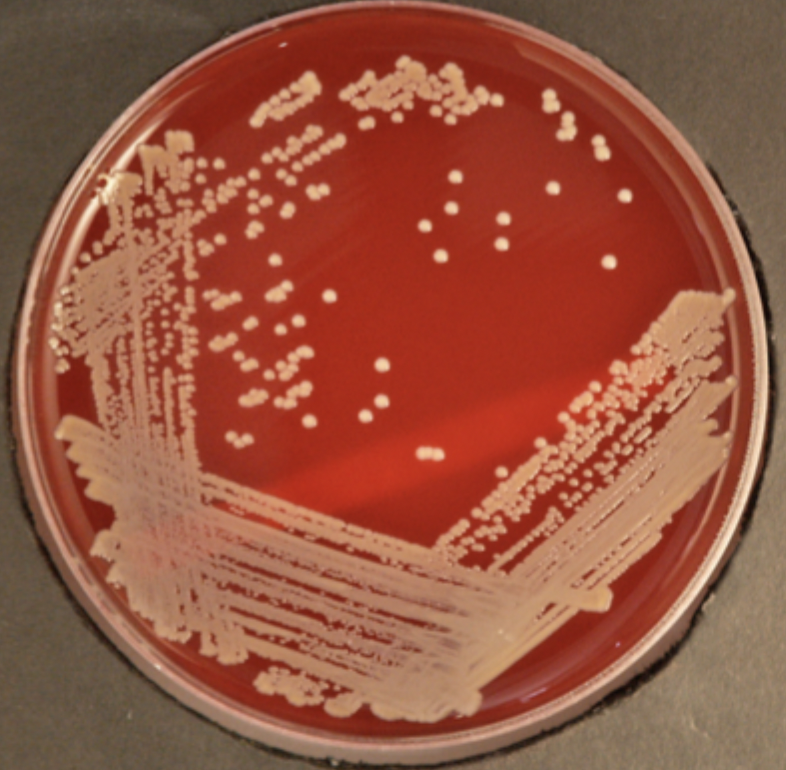
knowt flashcard image
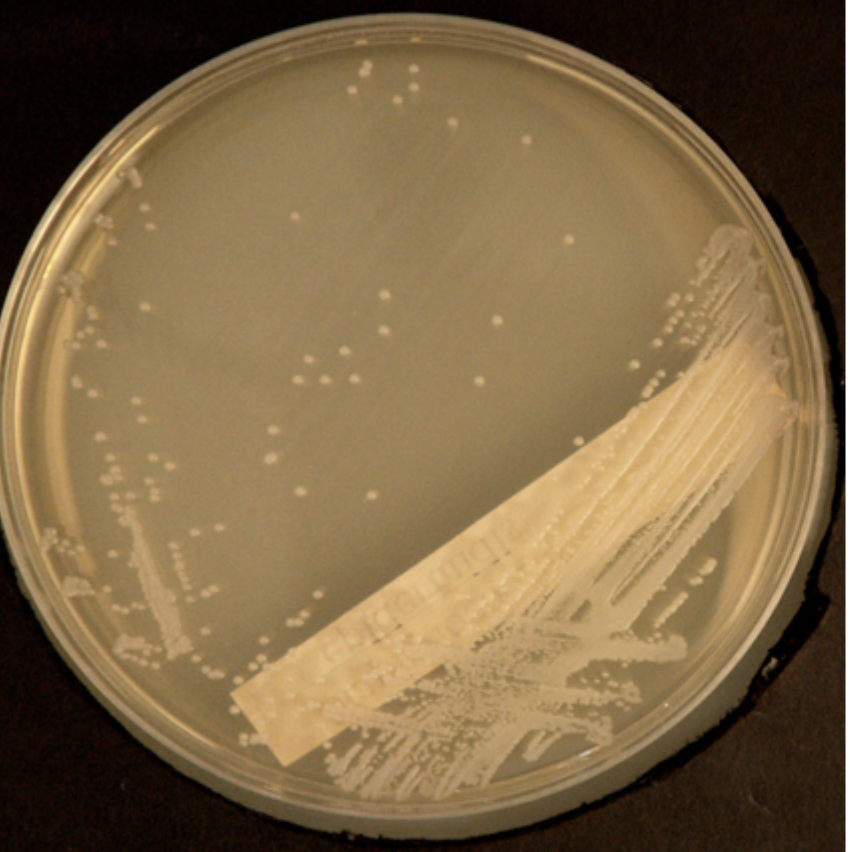
<p>White/off-white</p><p>Opaque</p><p>Convex</p><p>Round colonies with sharp, clear edges</p><p>Coagulase negative</p><p>Catalase positive</p><p>Gram +</p>
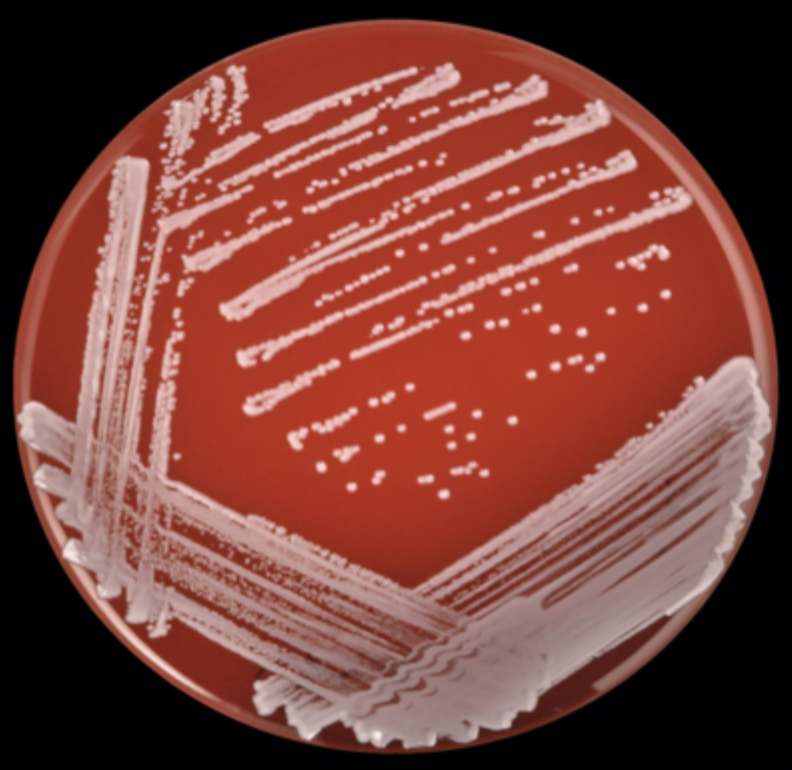
knowt flashcard image
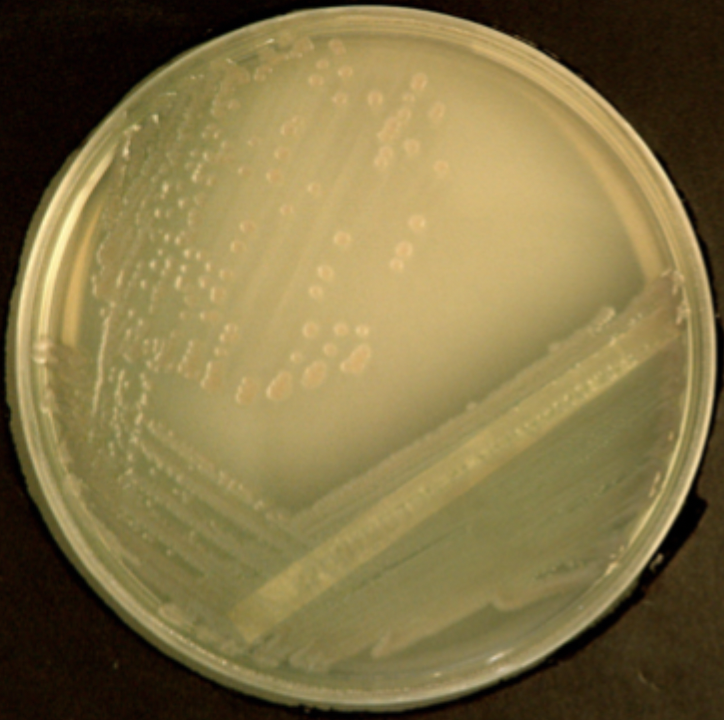
knowt flashcard image
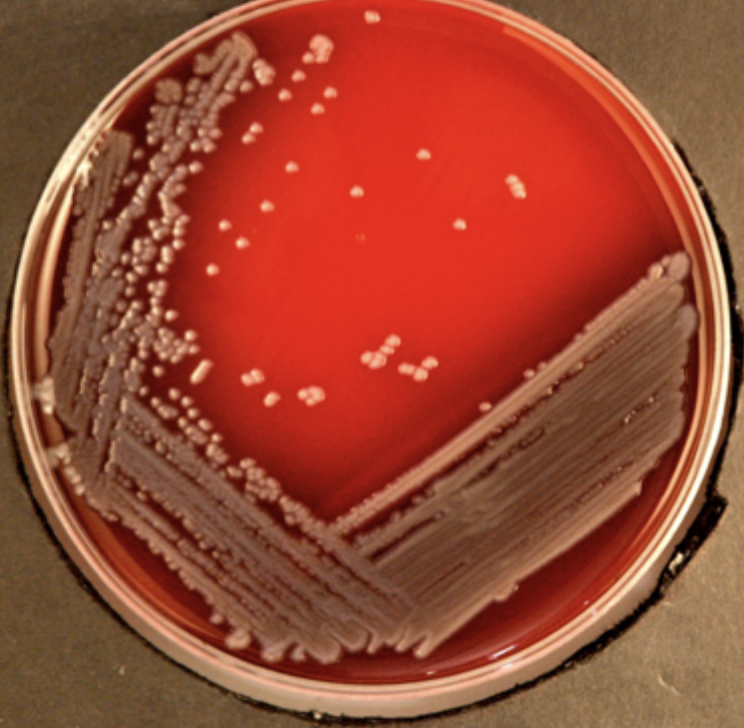
knowt flashcard image
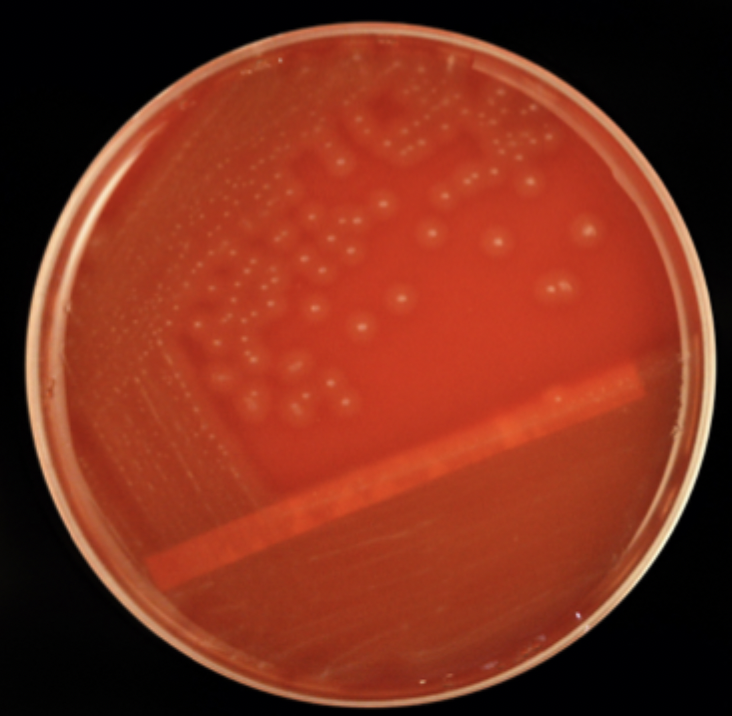
knowt flashcard image
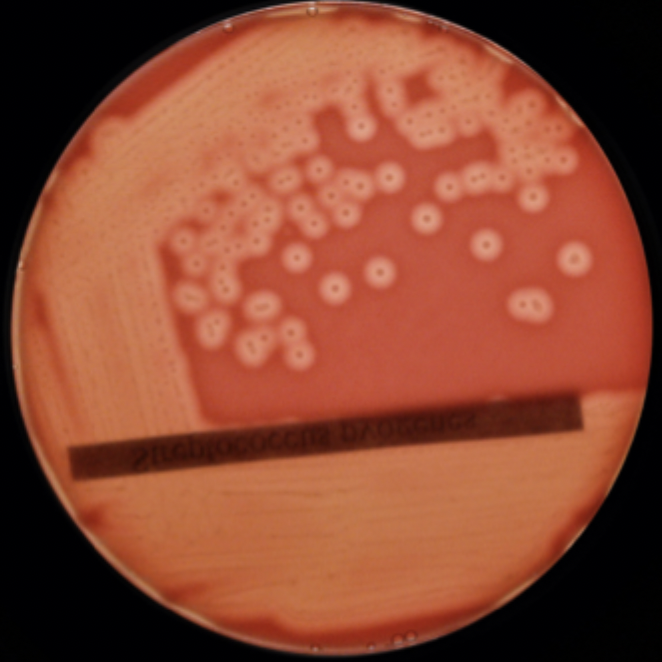
<p>Cream/ off white colonies</p><p>Raised opaque centres</p><p>Large zone of complete haemolysis</p><p>Lancefield group A</p><p>Ctalase negative</p><p>Gram +</p>

Practical 15: Pathogenic and commensal bacteria of the skin
1/41
There's no tags or description
Looks like no tags are added yet.
Name | Mastery | Learn | Test | Matching | Spaced | Call with Kai |
|---|
No analytics yet
Send a link to your students to track their progress
42 Terms
Staphylococcus aureus
Can be pathogenic and is a common cause of skin infections
Frequently found in nosocomial infections (MRSA)
Causes mastitis in humans and animals
Can cause food poisoning through ingestion of superantigen toxin
Staphylococcal coagulase activity
Pathogenic staphylococci produce coagulase enzymes that coagulate plasma
Production of coagulase is an indicator that a strain of Staph. is S.aureus
How does a positive result appear in coagulase activity test?
Formation of fibrin that polymerises and becomes evident as a delicate veil of protein.
What is the first step of Gram staining?
First make a thin smear of them on a glass slide and then fix them to the slide
What is the most frequent errors when creating thin smear for Gram staining?
Use of too much water on slide before adding the microorganism which will make the smear too thick.
Why add water to the slide when visualising bacteria?
Facilitates emulsification- Bacteria on an agar plate are packed into dense, sticky colonies so if directly added onto a slide, they would remain in a thick, opaque mound.
2.Achieving a "Monolayer"- you can spread the suspension thinly across the slide. As the water evaporates, it leaves behind a thin film of bacteria that are perfectly spaced for viewing.
3.Ensures even staining- Stains (like Gram stain or Methylene Blue) cannot penetrate thick clumps of bacteria effectively.
When is water not added to slides prior to adding sample?
Films made from liquid media, from swabs or from bodily fluids are spread directly.
Gram staining procedure
cover smear with crystal violet -
gently wash off
cover smear with gram iodine
gently wash off
decolorise with gram decoloriser until obvious reduction in blue colour
gently wash off
Cover smear with safranin counterstain
gently wash off and blot dry
Gram+ or Gram-
Gram+ = blue/violet
Gram- = pink/red
Colony characteritsics of pathogens and commensals of the skin
crowded colonies-smaller due to greater competition
Genetic variation can affect features of a colony like how smooth or rough it is
Pathogenic strains can produce toxins or enzymes to lyse or disrupt host cells (haemolysis- break RBC)
How to describe colony characteristics
-Size (mm)
-Shape
-Elevation (flat,convex,concave)
-Surface appearance (smooth,shiny,rough)
-Type of margin (entire,undulate)
-Colour (white,golden,off-white/cream)
-Opacity
-Presence or absence of changes in surrounding medium
E.coli histology

Staph. aureus histology

Staph. aureus nutrient agar
Golden yellow
Opaque
Convex
Round colonies with sharp,clear edges
Coagulase positive
Catalase positive
Gram +
Staph. aureus blood agar
Staph. epidermidis nutrient agar
White/off-white
Opaque
Convex
Round colonies with sharp, clear edges
Coagulase negative
Catalase positive
Gram +
Staph. epidermidis blood agar
Pseudomonas aeruginosa nutrient agar
Pseudomonas aeruginosa nutrient agar
Strep. pyogenes blood agar top lit
Strep. pyogenes blood agar back lit
Cream/ off white colonies
Raised opaque centres
Large zone of complete haemolysis
Lancefield group A
Ctalase negative
Gram +

Dairy cow with mastitis. Identify the 3 species?
E.coli
Staph. aureus
Staph. epidermidis
One Gram-positive coccus is a round yellow colony, and after staining appears as grape-like clusters, suggesting Staphylococcus aureus. The other Gram-positive coccus is white, and smaller than the yellow colonies, suggesting Staphylococcus epidermidis. The Gramnegative bacillus shows larger cream colonies suggesting E.coli or Salmonella (rather than Pseudomonas which would release a coloured pigment). In this context E.coli is most likely.
Viridans strep.
Small colonies
Grey-green partial haemolysis
Catalse negative
Gram +
Strep. pneumoniae
Small
Water-clear colonies
Often flat or convex
Partial haemolysis
Lancet shaped diplococci
Capsular polysaccharides types with antisera
Catalse negative
Gram +
Enterococcus faecalis
Gram +


Gram-


Gram + rod


Gram + rod






Gram - rod









Anaerobic growth

Some organisms will only grow at temp. below 37 degrees
Some mycobacterium
Issues that can arise when interpreting plate cultures

Haemolysis
Breakdown of erythrocytes due to bacterial proteins being secreted that are pore-forming or virulence associated enzymes that degrade phospholipids…
Incomplete or partial haemolysis

Complete haemolysis

Non-haemolytic
